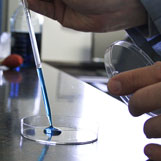

Nelson Analytical Lab is your full service Analytical Testing Laboratory providing a wide range of testing services for residential and industrial clients. We have three laboratory locations - Manchester NH, Keene NH, and Kennebunk, ME.
DRINKING
WATER TESTING

ENVIRONMENTAL ANALYSIS